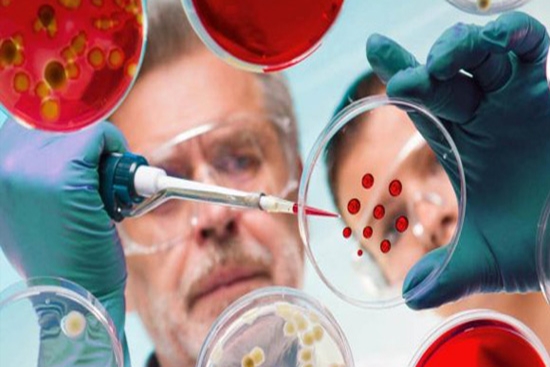

سمیناربین المللی عفونی با همفکری اساتید ایرانی و فرانسوی برگزار می شود
معاون بین الملل دانشگاه علوم پزشکی شهیدبهشتی از برگزاری نشست هم اندیشی اساتید عفونی ایرانی و فرانسوی برای برنامه ریزی سمینار بین المللی عفونی توسط اتاق ایران و فرانسه خبر داد.
معاون بین الملل دانشگاه علوم پزشکی شهیدبهشتی از برگزاری نشست هم اندیشی اساتید عفونی ایرانی و فرانسوی برای برنامه ریزی سمینار بین المللی عفونی توسط اتاق ایران و فرانسه خبر داد.
به گزارش روابط عمومی دانشگاه علوم پزشکی شهیدبهشتی، دکتر بابک شریف کاشانی معاون بین الملل دانشگاه علوم پزشکی شهیدبهشتی اظهار کرد: اتاق همکاری های ایران و فرانسه دانشگاه علوم پزشکی شهیدبهشتی برای برنامه ریزی سمینار بین المللی عفونی میزبان متخصصین و اساتید عفونی ایرانی از دانشگاههای علوم پزشکی کشور و جمعی از اساتید عفونی کشور فرانسه شد.

دکتر شریف کاشانی افزود: در نشست هم اندیشی اساتید عفونی ایرانی و فرانسوی درباره موضوعات و جزئیات سمینار بین المللی عفونی تصمیم گیری های لازم انجام شد.
معاون امور بین الملل دانشگاه با بیان این که سمینار مذکور در نیمه دوم سال 1401 برگزار خواهد شد ادامه داد: اساتید درباره طراحی و برگزاری یک وبینار ماقبل این سمیناربا موضوعات کرونا، ایدز و بیماری های عفونی مقاوم در برابر آنتی بیوتیک در بهار سال 1401 نیر به جمع بندی رسیدند.
وی با اشاره به شیوع بیماری کرونا و مشکلات ناشی از آن افزود: عفونت در پیوند ارگانها و مغز استخوان، عفونت های بیمارستانی، عفونت در بیماران با نقص سیستم ایمنی، کنترل عفونت و بیماریهای نوپدید و بازپدید از رئوس موضوعات این سمینار خواهد بود.
به گزارش روابط عمومی دانشگاه علوم پزشکی شهیدبهشتی، دکتر مسعود مردانی، دکتر پیام طبرسی، دکتر مینومحرز، دکتر آرش سیفی و جمعی از باتجربه ترین اساتید عفونی ایران و فرانسه در سمینار بین المللی عفونی ایران و فرانسه به سخنرانی می پردازند.
انتهای پیام/
کدخبرنگار:7701س.ق
